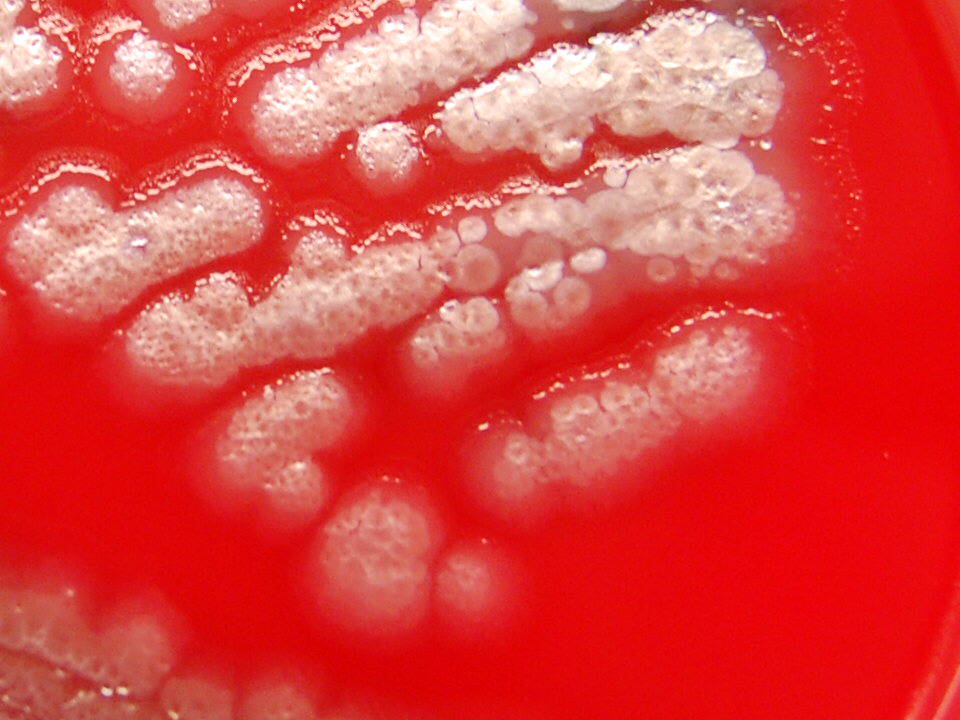

Scientific research
for bright future
world
Lorem ipsum dolor sit amet, consectetur adipiscing elit. Ut elit tellus, luctus nec ullamcorper mattis, pulvinar dapibus leo. Lorem ipsum dolor sit amet, consectetur adipiscing elit. Ut elit tellus, luctus nec ullamcorper mattis, pulvinar dapibus leo.
.
about us
objectives
- 1. Website can be used as a training tool for Clinical Laboratory Scientist.
- 2. Can be used as a bench guide/reference for working Clinical Laboratory Scientist.
- 3. The main body of the website is photographs and microphotographs of cells, bacteria, instruments, etc that we have taken during our career as a Clinical Laboratory Scientist.
categories

our working process
01
client projects
Lorem ipsum dolor sit amet, consectetur adipiscing elit, sed do eiusmod tempor.
02
client projects
Lorem ipsum dolor sit amet, consectetur adipiscing elit, sed do eiusmod tempor.
03
client projects
Lorem ipsum dolor sit amet, consectetur adipiscing elit, sed do eiusmod tempor.
04
client projects
Lorem ipsum dolor sit amet, consectetur adipiscing elit, sed do eiusmod tempor.
Awards Winning
0
+
Our Equipments
0
+
Field Expertise
0
+
Industry Expertise
0
+

